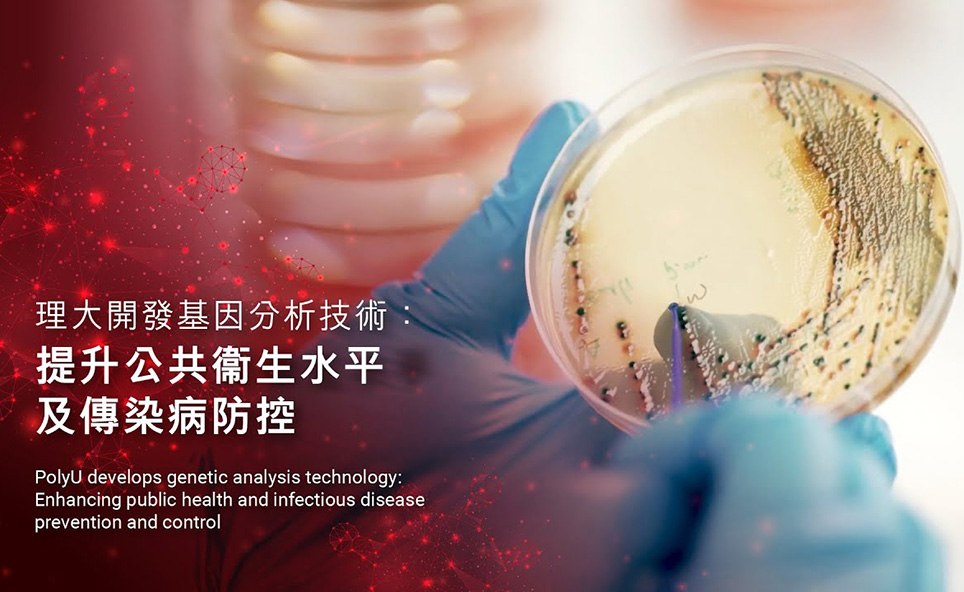

- Home
- About PolyU
Videos
PolyU Video Channel
About PolyU
Research and Knowledge Transfer
Event Highlights
Academicians and Distinguished Scholars
The Song of PolyU
Arts and Culture
Alumni Stories
Campus Life
Endowed Professorships
PolyVentures